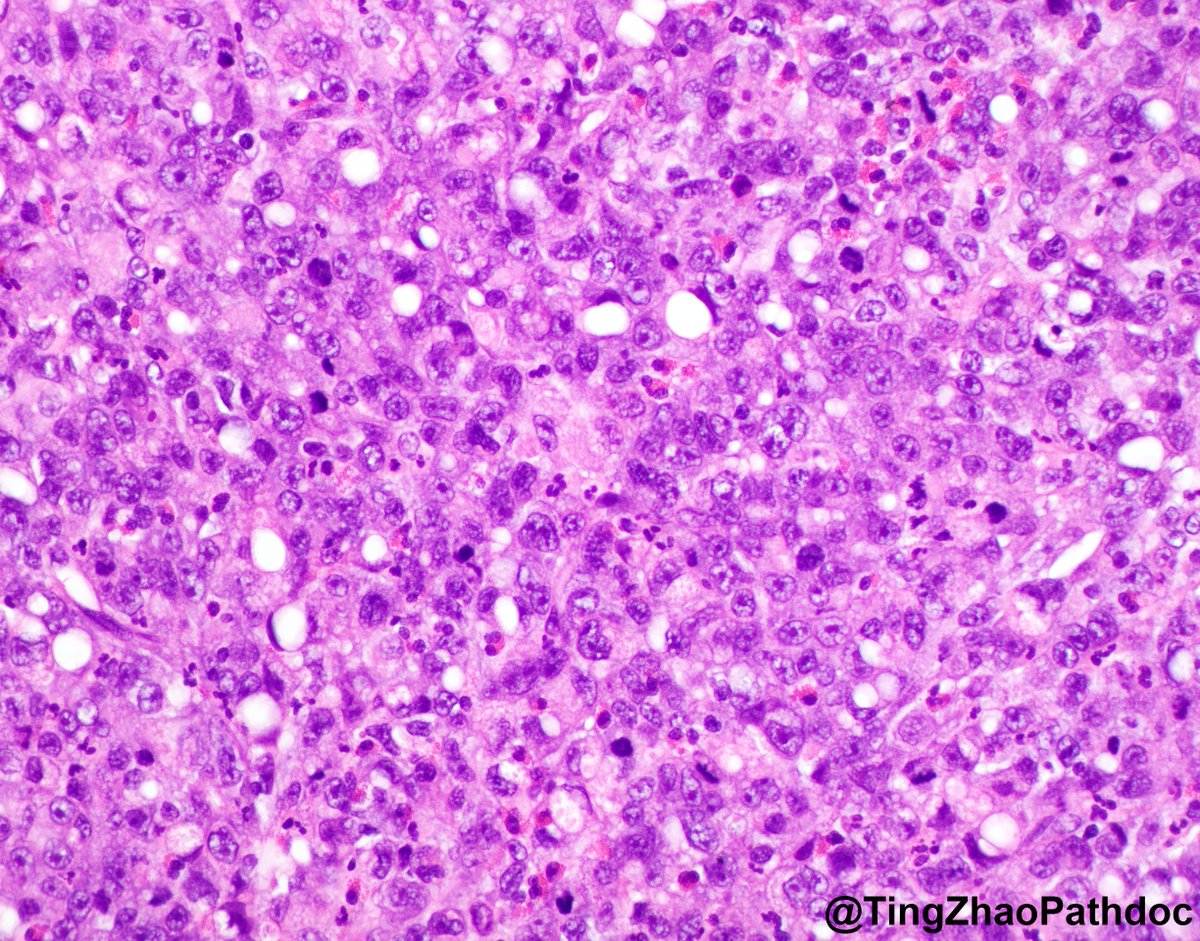
Ting Zhao, MD tweet media
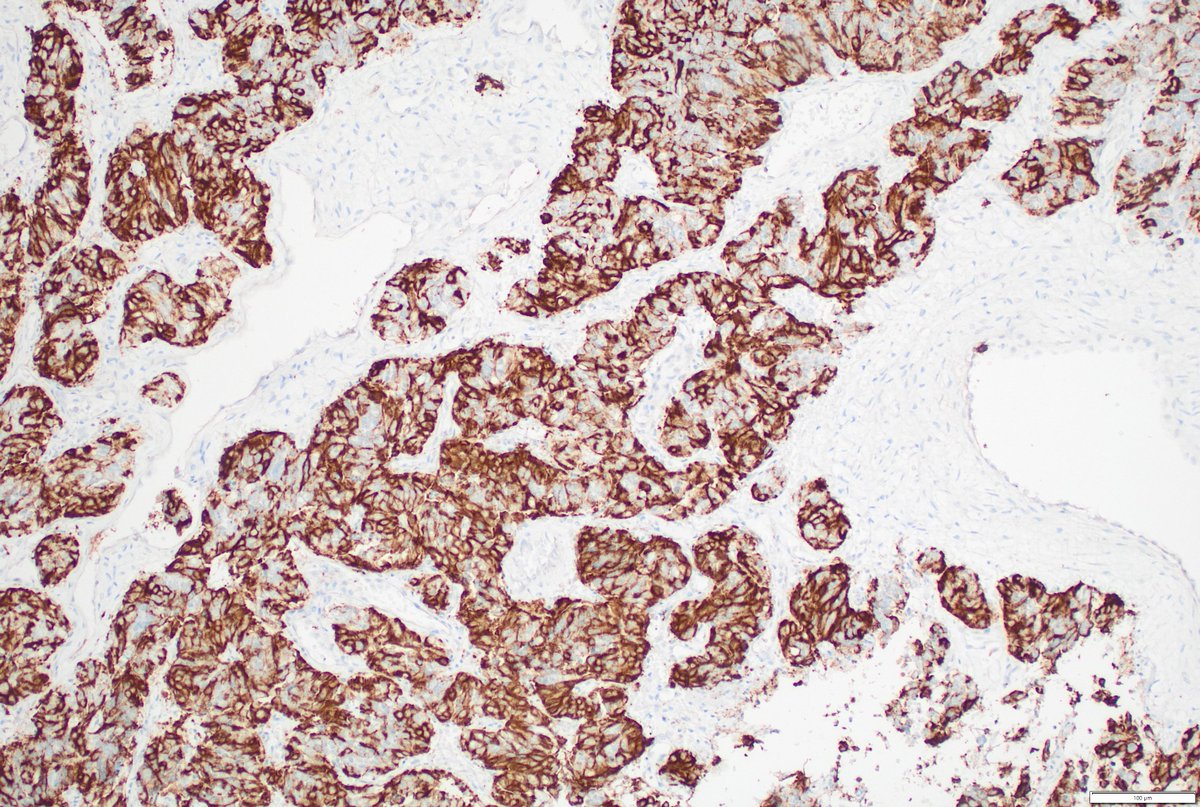
Humberto Trejo Bittar, MD, FCAP tweet media
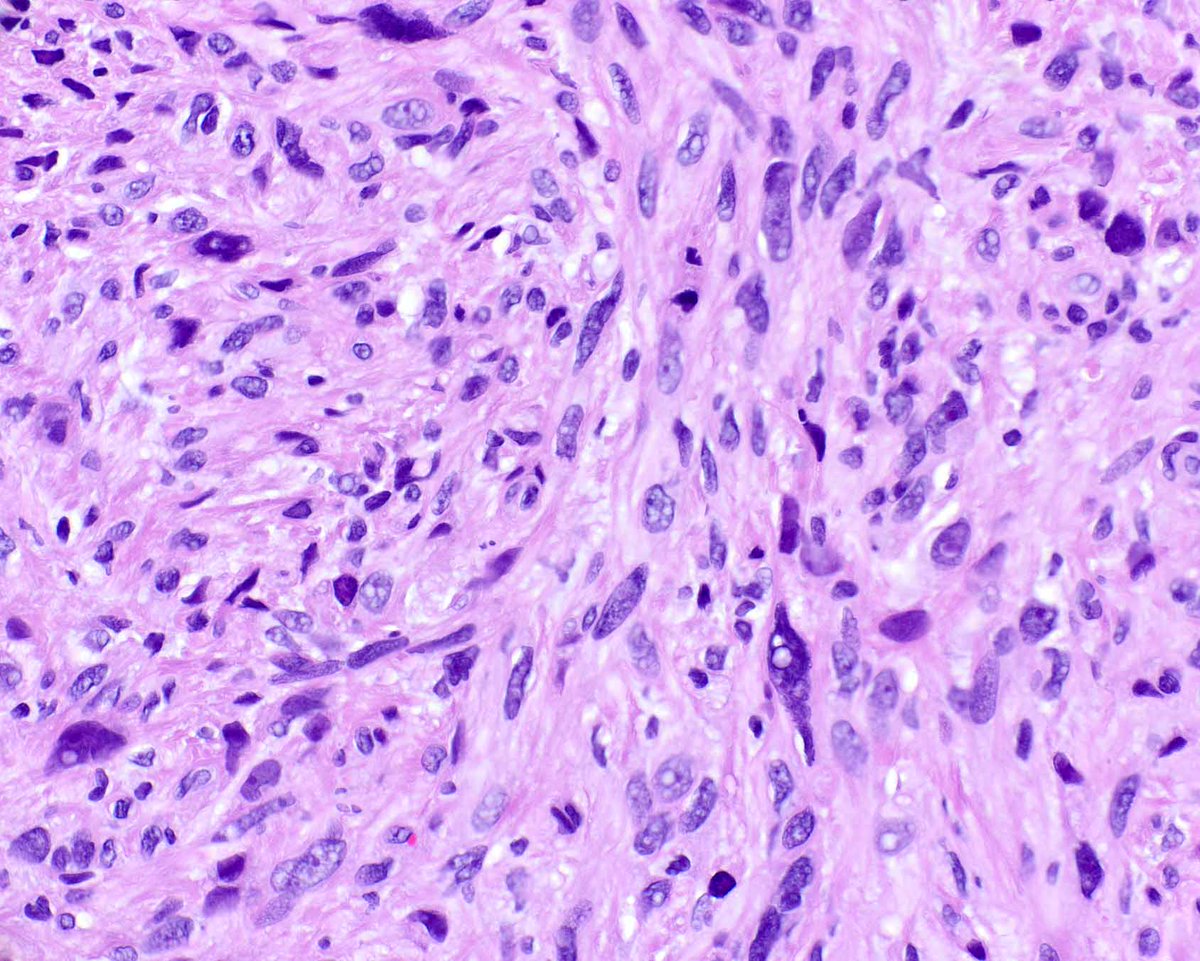
Elizabeth Montgomery, MD tweet media

پن کیا گیا ٹویٹ

Please consider giving your pathology images a forever home on WebPathology. Now you can load them directly from the site using Submit Images form. Give it a try. Webpathology.com: A Collection of Surgical Pathology Images #PathTwitter #PathX


English